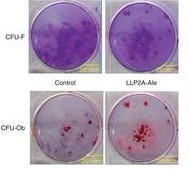

原始性骨髓间充质干细胞在不含有LLP2A-alendronate(LLP2A-Ale)的成骨培养基(对照)上或在含有LLP2A-Ale的成骨培养基上进行培养的图片。
美国加州大学戴维斯分校科学家领导的一个研究小组开发出一种利用一种分子增强骨生长的新技术:当该分子被注射进血液,它指导身体的干细胞运行到骨表面。一旦这种分子指导干细胞到达骨表面时,这些干细胞分化为成骨细胞而且合成促进骨生长的蛋白。2012年2月6日,这些研究成果在线发表在Nature Medicine期刊上。该研究利用骨质疏松症(osteoporosis)模式小鼠证实人们可以利用一种独特的方法增加骨质密度和阻止与衰老和雌激素缺乏相关联的骨质流失。
该研究主要研究员和第一作者Wei Yao说,“人们身上存在很多干细胞,即便是年老人们,但是它们不容易迁移到骨上。发现一种附着到干细胞上的分子并指导它们到达我们需要它们到达的目标确实是一次突破。”
研究人员正在探索将干细胞作为一种可能的疗法以便治疗很多种疾病和损伤,从外周动脉疾病、黄斑变性到血液疾病、皮肤损伤和病变的器官。指导干细胞运行并附着到骨表面从而导致骨形成是再生医学领域难以实现的目标之一。
加州大学生物化学和分子医学部门主任Kit Lam教授领导的一个研究小组开发出一种独特的杂合分子LLP2A-alendronate(译者注:LLP2A是拟肽配体,为一种小分子多肽模拟物;alendronate为阿伦膦酸钠)。这种杂合分子由两部分组成:LLP2A部分能够附着到骨髓中的间充质干细胞上,第二部分是由骨归巢(bone-homing)药物阿伦膦酸钠组成。研究人员便利用该杂合分子进行开展研究。当被注射进血液之后,它抓住间充质干细胞并指导这些干细胞到达骨表面,在那里这些干细胞执行自然的骨生成和修复功能。
Lam也是这篇论文的共同作者。他说,“我们的研究证实人们能够利用结合干细胞的分子指导干细胞到达动物内需要治疗的位点。它代表着将这种干细胞治疗变成现实的目标上迈出的非常重要的一步。”
当这种杂合分子注射进小鼠12周之后,相对于未注射该杂合分子的对照小鼠,接受注射的小鼠股骨(femur)和脊椎骨的骨质增加和骨强度得到改善。接受注射的小鼠即便是处于骨质流失发生的年龄时骨质形成能力也得到改善,就像绝经期模式小鼠表现的那样。
已知药物阿伦膦酸钠的商标名为福善美(Fosamax),经常被骨质疏松症妇女服用以便降低骨折发生的风险。研究小组将阿伦膦酸钠整合进杂合分子中是因为一旦进入血液,它将到达骨表面,在那里延缓骨断裂的速度。根据加州大学戴维斯分校骨骼肌衰老性疾病研究小组带头人和该研究共同研究员Nancy Lane的说法,杂合化合物中的阿伦膦酸钠含量较低而不可能抑制该化合物的治疗效果。
Lane说,“我们第一次可能发现一种指导人自己的干细胞到达骨表面的方法,在那里它们能够让骨再生。这种技术可能成为一种革命性的新疗法用来治疗骨质疏松症和其他需要新骨生成的疾病。”
骨质疏松症一种影响4400万美国人的主要公共健康问题。每两个妇女中就有一个在一生当中因为患上骨质疏松症而遭受骨折的折磨。尽管人们可以获得有效的包括阿伦膦酸钠在内的药物阻止骨折发生的风险,但是因为长期使用存在潜在的副作用而使得它们的使用受到限制。
妇女患上骨质疏松症的主要原因包括雌激素缺乏、衰老和治疗诸如风湿性关节炎之类的慢性炎症导致的类固醇过量。通常而言,由这些代谢疾病产生的骨质疏松症起源于骨重建循环的变化,这种变化削弱骨结构并增加骨折风险。
来自骨髓中的间充质干细胞诱导新的骨重建,这种重建让骨加厚和变得牢固。
研究人员注意到这种干细胞疗法的潜在用途并不限于治疗骨质疏松症。他们说,它可能对于因增强骨重建而受益的其他疾病也是极有价值的,如骨折、骨感染或癌症治疗。
该研究论文共同作者、内科教授和加州大学戴维斯分校再生治疗研究所主任Jan Nolta说,“将这些结果转化为人类疗法是大有希望的。我们证实这种潜在的疗法在啮齿类动物中是有效的,如今我们的目标就是对它进行临床试验。”
Lane说,“这项研究是干细胞生物学家、生化学家、转化科学家、骨生物学家和临床医生进行合作开展的。它确实是因为团队努力而取得的显著性研究成果。”

Directing mesenchymal stem cells to bone to augment bone formation and increase bone mass
Min Guan, Wei Yao, Ruiwu Liu, Kit S Lam, Jan Nolta, Junjing Jia, Brian Panganiban, Liping Meng, Ping Zhou, Mohammad Shahnazari, Robert O Ritchie & Nancy E Lane
Aging reduces the number of mesenchymal stem cells (MSCs) that can differentiate into osteoblasts in the bone marrow, which leads to impairment of osteogenesis. However, if MSCs could be directed toward osteogenic differentiation, they could be a viable therapeutic option for bone regeneration. We have developed a method to direct MSCs to the bone surface by attaching a synthetic high-affinity and specific peptidomimetic ligand (LLP2A) against integrin α4β1 on the MSC surface to a bisphosphonate (alendronate, Ale) that has a high affinity for bone. LLP2A-Ale induced MSC migration and osteogenic differentiation in vitro. A single intravenous injection of LLP2A-Ale increased trabecular bone formation and bone mass in both xenotransplantation studies and in immunocompetent mice. Additionally, LLP2A-Ale prevented trabecular bone loss after peak bone acquisition was achieved or as a result of estrogen deficiency. These results provide proof of principle that LLP2A-Ale can direct MSCs to the bone to form new bone and increase bone strength.
文献链接:https://www.nature.com/nm/journal/vaop/ncurrent/full/nm.2665.html








